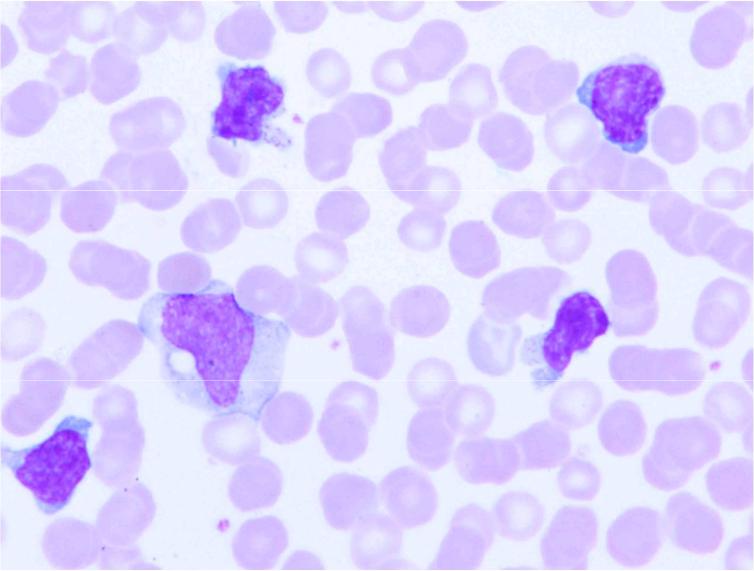
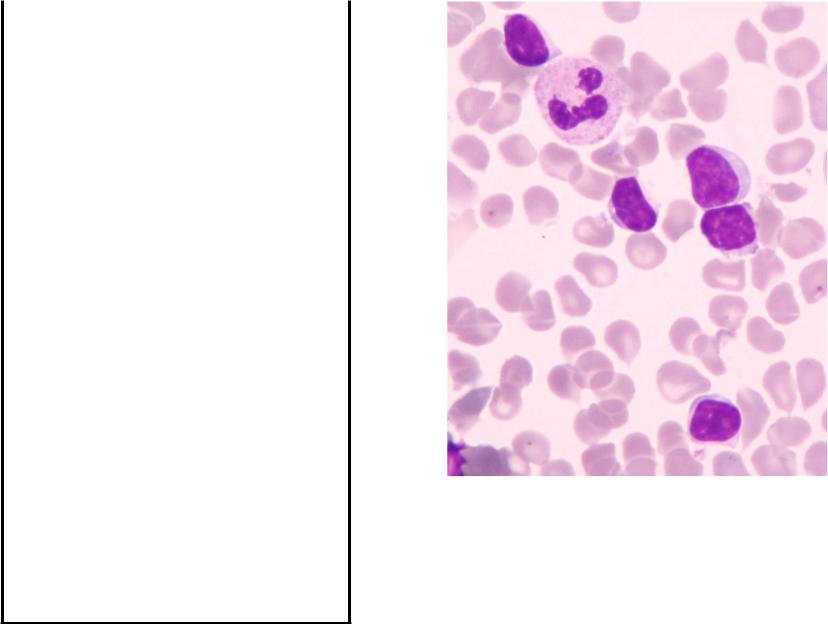

Материал: клинический+анализ+крови+3
Инфекционный мононуклеоз
Гранулярный Т-лимфоцит
Лимфоиммуноцит
Имеется избыточная базофилия цитоплазмы большинства лимфоцитов

Моноцитарно-макрофагальный росток
И.И.Мечников создал учение о макрофагической системе, которая в процессе научных исследований меняла своё название и содержание:
•ретикуло-эндотелиальная система
•ретикуло-гистиоцитарная система
•система фагоцитирующих мононуклеаров.
И последнее название не является абсолютно точным, т.к. среди макрофагов есть многоядерные (полинуклеары). Но этот термин более точен, чем другие, он отделяет мононуклеары лимфоидной линии (нефагоцитирующие) от макрофагов моноцитарного происхождения (фагирующих).

Моноциты и макрофаги
Моноциты
Макрофаг
Клетка Пирогова-Лангганса |
Эпителиоидныеклетки |
Эти клетки относятся к системе фагоцитирующих мононуклеаров, хотя клетки Пирогова-Лангханса являются многоядерными. Те и другие являются компонентами туберкулёзных гранулём – бугорков.
Макрофагив мазкеотпечатке лимфоузла из средостения, содержат угольную пыль.
Хронический лимфолейкоз (ХЛЛ)
Гемоглобин, г/л |
79 |
|
|
Эритроциты, х1012/л |
2,18 |
Цветовой показатель |
1,09 |
|
|
Ретикулоциты, % |
2,8 |
|
|
Лейкоциты, 109/л |
193,0 |
Миелобласты, % |
|
|
|
Промиелоциты, % |
|
|
|
Миелоциты, % |
|
|
|
Палочкоядерные, % |
|
|
|
Сегментоядерные, % |
5 |
|
|
Эозинофилы, % |
|
|
|
Базофилы, % |
|
|
|
Пролимфоциты , % |
7 |
|
|
Лимфоциты, % |
87 |
|
|
Моноциты, % |
1 |
|
|
Тромбоциты, 109/л |
129 |
СОЭ, мм/час |
62 |
|
|
Дополнительные сведения: На эритроцитах выявлены фиксированные антитела.
Мазок крови. Один нейтрофил и 5 лимфоцитов

Лимфобластный лейкоз (ОЛЛ)
Гемоглобин, г/л |
71 |
|
|
Эритроциты, х1012/л |
2,43 |
Цветовой показатель |
0,87 |
|
|
Ретикулоциты, % |
0,4 |
|
|
Лейкоциты, 109/л |
0,6 |
Миелобласты, % |
|
|
|
Промиелоциты, % |
|
|
|
Миелоциты, % |
|
|
|
Палочкоядерные |
2 |
|
|
Сегментоядерные |
3 |
|
|
Эозинофилы |
1 |
|
|
Базофилы, % |
|
|
|
Лимфобласты |
2 |
|
|
Лимфоциты |
2 |
|
|
Моноциты, % |
|
|
|
Тромбоциты, 109/л |
64 |
СОЭ, мм/час |
60 |
|
|
Дополнительные сведения: в пунктате грудины лимфобласты 93,4%. При подсчёте лейкоцитарной формулы найдено всего 10 клеток.
Костный мозг,
окраска азурэозином по Романовскому
Типичная гранулярная реакция на гликоген (PAS) в 4 из 9 бластов